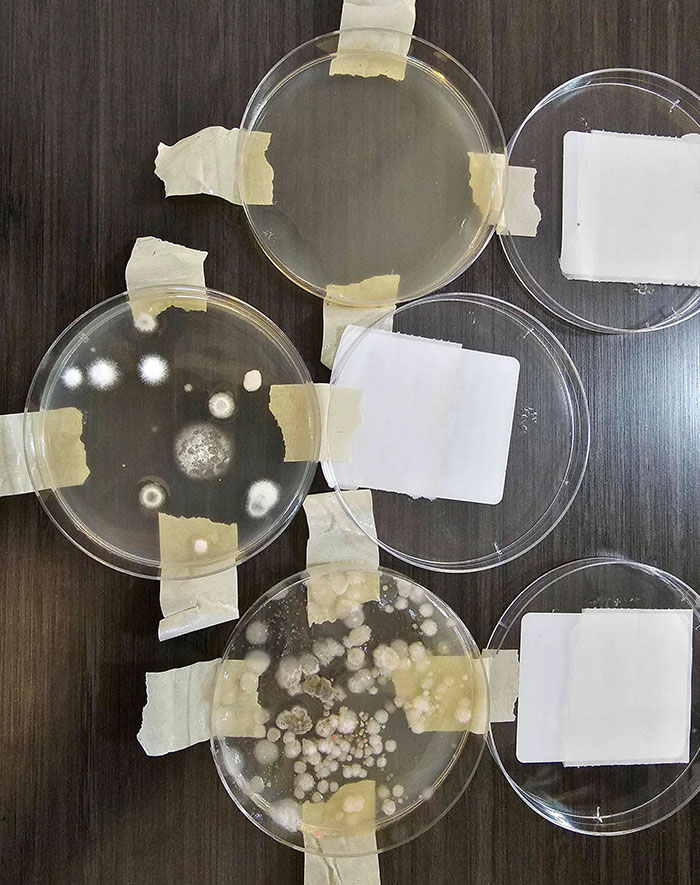
Air Quality Tests From My Airbnb Where The Host Claimed Not To Smell Any Mold. Support Refused My Refund

The introduction of Airbnb disrupted and changed the hospitality industry in many positive ways. It started offering more authentic, convenient, and cheaper experiences for travelers and allowed homeowners to earn some extra income by renting out their unused space, from budget rooms or apartments to fancy villas. I’d say that’s a win-win for everyone.
However, as with most things in life, there are bound to be some disappointments or things that don’t particularly go to plan. From mushrooms growing in the bathroom door to extortionate cleaning fees and child-sized furniture, scroll down to find some of the strangest Airbnb conditions guests had to endure.
This post may include affiliate links.
I Feel Really Creeped Out, As I Didn't Notice It Earlier
From A French Airbnb Alternative
This Hidden Camera Disguised As A Clock In My Airbnb
According to a 2021 study, a lot can go wrong when staying in an Airbnb. A data scientist, Asher Fergusson, collaborated with a few researchers to find out the problems that guests are most likely to face when staying at short-term rentals.
The project even received funding from ASIS International, and over 2 and a half years the team used machine learning and natural language processing techniques to analyze X (previously Twitter) posts associated with guest complaints.
The Bathroom In Our Airbnb Was Rather Small
Not Even Motel Is This Bad
A Cleaning Fee Just As Much As The Room Cost?
“Our number one goal when starting out with this research was to find out what’s most likely to go wrong for Airbnb guests,” Fergusson said to Forbes Women.
In total, they analyzed over 127,183 posts published between January 1, 2015 and September 20, 2020 and broke them down into types. The results ranged from frustrating to dangerous.
Over The Bathtub In My Airbnb
I Found A Pair Of Handcuffs Attached To A Leg Of The Bed In My Airbnb In Tijuana
This Bedroom On Airbnb In A Place Called “Stabbin Cabin”. Sounds About Right
I'd be scared something would fall on top of me if I moved about too much - or got out of bed in the dark to go to the bathroom
“We found thousands of cases of account hacking with vacation dollars being stolen via fraudulent bookings as well as many other scams,” says Fergusson. “Then there were police interventions, bodily harm, threats, bug infestations, invasions of privacy via hidden cameras, long-term negative health impacts after the customer checked out of the Airbnb and so much more. Even in 2021, the amount of illegal, unsafe or fake listings on the platform is staggering—more than any of us probably realize.”
Airbnb Hosts Are Likely Selling The Audio Of Your Private Life
The Airbnb Has A Window From The Shower To The Living Room
Found An Interesting Airbnb In Waterloo
The report revealed that the most common problems were linked to customer service (72.2%), which provided limited support during emergencies or was rude or even unreachable. Scams made up 22.3% of complaints, from fake listings to hacked accounts. 10.4% of guests were left unsatisfied because the host cancelled their stay. 6.1% experienced unsafe conditions ranging from pest infestations to hidden cameras. While 3.7% of complaints reported discrimination against race and sexuality.
At My Airbnb There’s A Mushroom Growing Out Of The Bathroom Door
Just Saw This On Airbnb. What £2100 Per Month Gets You In Central London
Air Quality Tests From My Airbnb Where The Host Claimed Not To Smell Any Mold. Support Refused My Refund
Ferguson published the report, saying that it was important that Airbnb users know what awaits them when they’re using the platform. “Countless Airbnb guest complaints we reviewed on Twitter suggested that the company is very good at circumventing responsibility,” he says. “Their customer service will often go silent or cite some obscure, confusingly worded terms of service when guests rightfully request refunds for services not rendered. It’s important for users to understand renting an Airbnb is not the same as booking a hotel.”
Got An Airbnb Just For The Tub
They Said There Was A Sea View At Our Airbnb
Airbnb Wasn’t What We Were Expecting
I bet this was described as a child's room and they just didn't care because it was cheaper. Those chairs are visibly tiny (if they were full-size chairs, the bed would be about 4 metres long) and the bed even has rails to stop a child rolling out of bed. And now to be funny a large man is breaking a bed meant only to hold the weight of a 5-year-old.
He believes that it’s easier to scam people with short-term rentals as they have little supervision as opposed to hotels. Reputable hospitality institutions are less likely to be massively deceiving people or constantly cancel reservations hours before guests have to arrive. Moreover, it’s rare to find a hotel that doesn’t have safety precautions like a smoke or carbon monoxide detector.
While My Family With Young Kids Were Staying At This Airbnb, An Old Man Walked Into The Backyard And Started Draining The Pool
The "Bathroom" In My Airbnb Will 100% Result In Encounters With The Host
The Bathroom Door In My Airbnb Is Ineffective
In order to stay safe and protected, Ferguson recommends treating rental reviews as a mystery novel. This means reading between the lines what the previous guest has written, as most of them don’t express the negatives directly. In addition, he advises to never book a place with zero reviews. Instead, he says to aim for rentals with a 4.85-star review average or higher.
Deadbolt, Mice, Leaking Ceiling, Roaches I Caught Everything On Camera. I've Messaged The Host But They're Not Responding And Calling Support Is Worse Than Useless So Here We Are
This Sink In Our Airbnb
My Airbnb Estimate - No Wonder Bookings Are Down
It’s also important to look at the hosts’s overall reviews, not just the listing’s. Be sure to reach out to the host before the stay and document anything that goes wrong or seems suspicious with video evidence. This helps to get a refund with less hassle.
Airbnb Host Tried To Charge Us For Changing Settings On A Thermostat
When One Of The Troops Books An Airbnb Specifically For The Pool Table
Disco Toilet In An Airbnb
Better Hope You Don’t Stab Yourself In The Shower Of This Airbnb Rental
I Booked An Airbnb A Year In Advance Of The Eclipse In April. The Host Yesterday Canceled Because They Realized They Could Make More Due To The Eclipse
Airbnb Host Tried To Double The Price
Airbnb With “Motion Detector” Ring Camera Above A Full Length Mirror. $500 For Tampering With Or Unplugging It. Good Thing I Have Post-It Notes
The Host Said That This Airbnb Is "Full Of Traditional And Modern Artwork." "Tastefully Decorated" And "Quirky Interesting Decor"
When You Rent An Airbnb In The Philippines, You Get Free Protein Every Morning. Glue Trap After 24 Hours
It Was Supposed To Be A Cozy Flat For A Couple And Now I Have To Stay Here For 3 Weeks Because No Other Option Is Available. All This Stuff Belongs To The Owner
From OP: More on this: So I am on a scholarship in Germany with my SO and we rented a single room with separate bathroom in a flat very close to my Institute. The description indicated that we can use the whole space, especially the kitchen and TV. So the room is, well, agreeable, not the cleanest but we can handle it - but the whole apartament is just a freaking joke. The owner is a stockbroker, seems a little bit off, he sleeps on a couch in the living room. He's German and he was trying to get me into a conversation about German invasion during II WW. We wanted to get a refund but then we realized that it's a waste of time, the procedure is long and we can live through it. But at least I can release my disappointment here.
Airbnb Host Asks This After A $350 Cleaning Fee While Being Asked To Strip All Sheets, Take Out All Trash And Run Dishwasher
The Airbnb I'm Renting
My Airbnb Host Is Using T-Shirts As Pillowcases, And One Has A Body Odor Smell. I Guess I’ll Be Dreaming Of Sweaty Armpits Tonight
From An Airbnb I Stayed At
The Airbnb I'm Staying In Says It's A Laundry Room, So I'll Be Wearing Dirty Clothes All Week Because I For Sure Won't Be Going There
My Airbnb Assured Me They Have A “Very Safe” Baby Gate
Mushrooms Growing In The Shower Of Our 5-Star-Rated Airbnb
There's A Mirror Screwed Into The Ceiling Above The Toilet In My Airbnb
Dirty Floor At Airbnb “Is Typical And Not An Indicator Of Dirt”
I’m posting to get some reactions to an experience I had at an Airbnb rental. I rented a place for my father and me to stay while he recovered from surgery, and I expected a high level of hygiene accordingly to keep him safe. I ended up spending hours after checking in cleaning (after I took an Uber to get cleaning supplies). The company representative was trying to tell me that it’s normal for the Swiffer wipes to appear "to be removing dirt." I’m pretty baffled by their response, as I know that floor was filthy. But could there be an element of truth to what they’re saying? Do some types of flooring give off color like that?
On The Wall Of A Friend's Airbnb Rental
Airbnb Description Said "Views Of The Main Church From The Bedroom Window." Technically, It Was Not A Lie
The Place I Found On Airbnb
This Marbled Shower At An Airbnb I Stayed In. I Thought It Was Dirty And Tried To Scrub It Clean Until I Realized It Was "Supposed" To Look Like That
This Bathroom Tile At My Airbnb
Well, The Airbnb Looked Nice Online
C'mon, BP. This is intentionally misleading. According to the original post, OP rented the main, normal sized, house, and this is a children's playhouse that was on the property, and he took the pic for fun.
Looking For An Airbnb In London. Did Someone Really Just Put A Bed In Their Bathroom?
After A 14-Hour Drive, We Found Bed Bugs At Our Airbnb
My wife worked for months to pick out the right house for our family, so it was disheartening to have it ruined like that. We were allowed to change to a different house nearby, but it was a cheaper house, had a worse view, and a worse pool. And because we changed houses, there's no way to leave a review on the original house.
I Found This Painted, Feathered Baby Doll Head In The Freezer At My Airbnb. Am I Going To Die?
Staying In An Airbnb. I Woke Up This Morning To Find The Cover To Access The Attic Completely Moved
If You Needed Another Reason To Hate Airbnb. 2 Weeks Before Our Reservation Our Hosts Tells Us He Over-Booked
At An Airbnb
What is the obscured word starts with an M ends in a Y? Masterbatery? Masterbationary?
Looking For Somewhere To Stay On Airbnb And Found This House Of Nope
This Airbnb Had Framed Skulls Above The Fireplace
In the description, the owner clarified that there were 36 of them, that they were human skulls, and that the frame was made of oak.
My Airbnb Host Said The "Keys Are In The Grey And Black Safe Near The White Door"
My Airbnb Stairs. Every Step Is A Different Height, Width, And Depth
This Creepy Family Photo In My Airbnb
All The Rooms In My Airbnb (Including Mine) Have A Key Locked Behind A Lock With A Code That's A Room Number
I Tried To Open The Air Conditioner Vent At The Airbnb I'm Staying At On Vacation And Found This
At The Airbnb I Stayed At
Seen In An Airbnb. Upcycling Fail
Airbnb Said I'd Have A Balcony, But Seriously
In Our Airbnb In The Middle Of Nowhere
"Thank you for the tips! It helps to keep this place clean. Some people give us 1 or 2 dollars. Tips, this amount is not helping too much. We do charge a small amount for each room. We deserve more than 1 or 2 dollars in tips. Thank you.
Come back again."
A "Perfect" Fit For A TV (At An Airbnb My Girlfriend Stayed In)
Booked A Beautiful 2 Bedroom Condo On Airbnb. Host Cancelled And “Upgraded” Me To This “4 Bedroom Dream Home”
Oh My God, The Airbnb Bathroom Is Tiled With Rocks
This Narrow Hallway In My Friend’s Airbnb Is Only 1.2 Meters (3.9 Ft) Wide, You Can Barely Walk Through When The Attic Ladder Is Down
Notice To Airbnb Guests
One night stay £25-£30 (depending on the room size). Your thoughts?
Yes, as they themselves say, this is a short stay place. Definitely.
This Shower At My Airbnb
In situations like this, we really need to know how the person's height. If they are 1.9m tall, then will find lots of showers are not built for people of their height. I often struggle with bathroom mirrors. At 1.55m tall, often all I can see is the top my head in the mirror.
Airbnb Room Online Compared To Real Life. A Buddy Of Mine Is Currently In Rome And Pays 200€ Per Night For That Beauty
The bed is rock solid and apparently, the bathroom is a biological research center for mold.
The Toilet Paper At Our $3k/Week Airbnb
John Wayne toilet paper. Rough, tough, and doesn't take c$@p from anyone.
The Airbnb I Stayed At Last Weekend. This Renter Likes To Patch Sheetrock Holes With Cardboard And Fake Flowers
This "Abstract" Billiards Table At An Airbnb I Was At. As It Also Turns Out, Thick Globs Of Hideous Paint Don't Allow For A Very Smooth Table Roll
My Airbnb With This Weird Perspective Corridor
anyone else see the twins at the end of the hall? no? just me then. Heeeerrrre's Johnny!
Found This In An Airbnb In Amsterdam. You Can't Even Sit Down
This Corner Table At An Airbnb
Airbnb A/C Is Locked At 80 Degrees F. Staying In Jacksonville, Florida. The Host Won’t Give Us The Pin For The Thermostat
I Booked An Airbnb, Then Received This Message From The Host. A Few Hours Later, They Cancelled The Stay
Airbnb With Aquatic-Themed Floor
Our (Not Cheap) Airbnb Has A Tip Jar
I Have An Interesting Airbnb Tonight
This Tapestry Hanging In The Room Of An Airbnb
Bathroom In Airbnb's Party House Doesn't Have A Shower Cabin Or Elevated Water Drainage, Which Leaves The Whole Room Flooded After Showering
We had the same trouble in our hôtel in Florence. And it made the floor dangerously slippery as well.
Checked Into Our Airbnb And Found These Tiles
Airbnb House. TV Is Hung Halfway Up A Two-Story High Fireplace, Nearly Level With The Upper Floor
This Inconsistent Wall Clock At My Airbnb
Shower Curtains Falling At An Airbnb We Are Staying At
This Bathroom Door In An Airbnb In Vienna
The Side Table In Our Airbnb Is A Phone (Non-Functioning)
This Wall Art In My Sicilian Airbnb
I Was In An Airbnb And Found This Map Missing A Lot Of Islands And Even The UK And Ireland
This Window In My Airbnb
Gotta Love Random Airbnbs
Found On Airbnb In Maine. The Bat Was Cracked Too
Sitting Atop The Bathroom Mirror At Our Airbnb
Collector doll. I used to have some of those in the 60s, brought back by my travelling relatives. Remember those boxes too.
These are the reasons why I only stay in hotels. Well, these and room service.
These are the reasons why I only stay in hotels. Well, these and room service.

 Dark Mode
Dark Mode 

 No fees, cancel anytime
No fees, cancel anytime